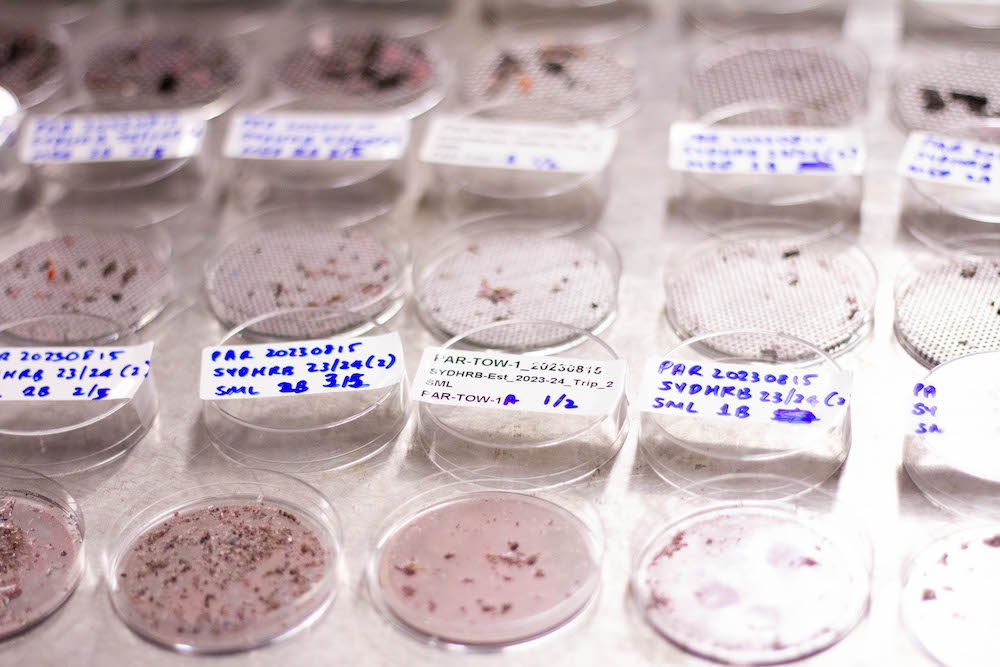

An Australian-first microplastic assessment has found the Cooks River, Dee Why Lagoon, Muddy Creek and upper Parramatta River are NSW’s most contaminated coastal waterways.
The NSW Environment Protection Authority (EPA) has partnered with the NSW Department of Climate Change, Energy, the Environment and Water (DCCEEW) to deliver the Broadscale Microplastic Assessment.
The report ranks coastal waterways by microplastic concentration in the top 15 centimetres of surface water, from most to least contaminated.
The three-year comprehensive study will help environment authorities understand how microplastics end up in waterways and where to focus further research.
NSW EPA Chief Executive Tony Chappel said the results will provide important insights to guide future work.
“Microplastics are one of the fastest-emerging threats to marine life and our environment, often washed from land into rivers and then into the ocean through stormwater drains,” Mr Chappel said.

“For the first time, we’ve sampled 120 catchments from the Tweed to the Victorian border to identify the most affected sites, the types of microplastics present, and where we can make the greatest impact.
“Microplastics were detected in every waterway sampled, demonstrating the widespread nature of plastic contamination across urban, regional, and remote catchments.”
The top 10 hotspots were found to be:
- Cooks River
- Dee Why Lagoon
- Muddy Creek
- Toongabbie Creek (Upper Parramatta River)
- Throsby Creek
- Coffs Creek
- South West Rocks Creek
- Manly Lagoon
- Parramatta River
- Middle Harbour Creek
In contrast, the least contaminated are Myall Lake, Nadgee Lake, Middle Lagoon, Myall Broadwater and Wallaga Lake, all in minimally disturbed catchments on the state’s north and south coasts.
More than 31,000 particles were identified, including foam packaging and plastic pellets, also known as nurdles. These are priority microplastics because they can be traced and stopped at the source.
Mr Chappel said these findings will shape the next wave of action, turning science into practical steps and building on the state’s ongoing efforts to tackle plastics.
“Putting microplastics under the microscope gives us a clear indication on where targeting our efforts is needed,” Mr Chappel added.
“We’ll use this groundbreaking data to develop models of sources and pathways to better target preventable pollution, work with water managers on local solutions and strengthen policies that keep microplastics out of our ecosystems.
“One way we’ll do this is by mapping how litter flows through the Cooks River and Manly Lagoon – tracing plastic from our streets to the sea so we can pinpoint sources and pathways, and direct action where it counts.”
NSW is already pursuing a range of other measures to reduce plastic pollution, including increased compliance on plastic bans, launching community awareness campaigns, and awarding litter prevention grants.
To read the report, visit: www.epa.nsw.gov.au/broadscale-microplastics-assessment